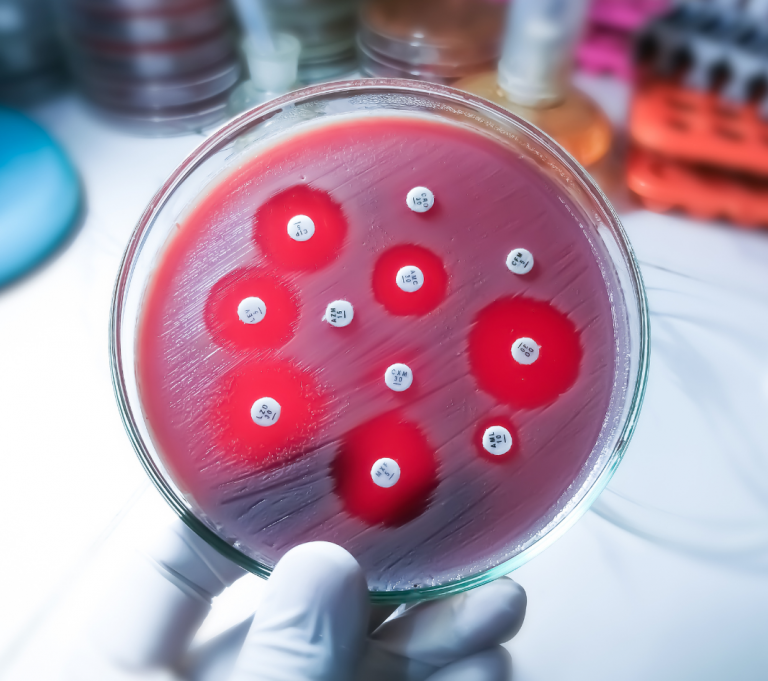
rezistencia na antibiotika

Čo sú to klostrídie
Klostrídie (Clostridium a príbuzné rody, napr. Clostridioides) sú skupina baktérií, ktoré majú pár zaujímavých (a niekedy nebezpečných) vlastností:
Žijú bez kyslíka – sú anaeróbne, takže kyslík im skôr škodí.
Tvoria spóry – také malé „obranné kapsule“, v ktorých dokážu prežiť extrémne podmienky: sucho, teplo, dezinfekciu, dokonca aj roky v pôde.
Bežne sú v pôde, vode aj črevách ľudí a zvierat.
Niektoré druhy sú neškodné, iné sú známe patogény:
C. botulinum – botulizmus (najsilnejší známy bakteriálny jed)
C. tetani – tetanus
C. perfringens – otravy jedlom, plynatá snäť
C. difficile – hnačky po antibiotikách
Obrazne povedané: klostrídie sú majstri prežitia a niektoré z nich sú aj majstri v produkovaní toxínov, ktoré ľudské telo určite nepotešia.
U zdravých ľudí s normálne fungujúcou črevnou mikrobiotou býva väčšinou neškodná, pretože ju iné „dobré“ baktérie udržujú pod kontrolou a nedovolia jej premnožiť sa.
Aké sú príčiny infekcie Clostridium difficile?
Infekcia Clostridium difficile patrí medzi najčastejšie nemocničné nákazy. Najčastejšie sa vyskytuje u osôb, ktoré užívajú antibiotiká alebo absolvujú chemoterapiu. Antibiotiká narúšajú črevný mikrobióm, tým že ničia aj prospešné – životne dôležité črevné baktérie. To umožňuje Clostridium difficile, aby sa množila a produkovala nebezpečné toxíny. Baktérie Clostridium difficile, sú často rezistentné na bežnú antibiotickú liečbu.
Tieto klostrídie môžu prežiť na povrchoch ako sú kľučky dverí, toalety, postele a iné predmety v okolí. Kontakt s týmito povrchmi a následné dotknutie sa úst môže viesť k infekcii. V nemocničnom prostredí je prenos obzvlášť rizikový kvôli vysokej koncentrácii pacientov a častému kontaktu s kontaminovanými povrchmi. Z tohto dôvodu je v zdravotníckych zariadeniach obzvlášť dôležitá dezinfekcia a hygienu rúk, aby sa minimalizovalo riziko šírenia infekcie Clostridium difficile.
Ako sa infekcia Clostridium difficile prejavuje a aké sú príznaky?
Infekcia Clostridium difficile sa môže prejavovať rôznymi príznakmi, od miernej hnačky po ťažký zápal čreva. Medzi najčastejšie príznaky Clostridium difficile patria :
- Vodnatá hnačka: Často niekoľko krát denne.
- Bolesť brucha: Zvyčajne kŕčovitého charakteru.
- Horúčka: Pri závažnej infekcii sa môže vyskytovať zvýšená teplota.
- Nevoľnosť a strata chuti do jedla.
- Krv v stolici: Pri ťažkej forme zápalu čreva.

Ako sa zbaviť Clostridium difficile
Zbaviť sa Clostridioides difficile je trochu zložitejšie než pri bežnej baktériálnej ifekcii, pretože Clostridium difficile:
vytvára odolné spóry, ktoré prežijú aj mnoho dezinfekcií
- je rezistentná na bežnú antibiotickú liečbu
rada sa vracia (recidíva je častá)
Clostridium difficile liečba
Diagnostika infekcie Clostridium difficile sa zvykne vykonávať pomocou laboratórnych testov stolice, ktoré detekujú prítomnosť toxínov produkovaných touto baktériou. Liečba zahŕňa:
- Ukončenie užívania problémových antibiotík: Ak je to možné.
- Liečba antibiotikami špecifickými pre C. difficile: Napríklad metronidazol alebo vankomycín.
- Strava bohatá na sacharidy: Strava s nízkym obsahom tukov a bielkovín by mohli pomôcť zvládnuť infekciu spôsobenú Clostridioides difficile.
- Probiotiká: Najspoľahlivejšou, najúčinnejšou a prirodzenou liečbou je užívanie probiotík s cieľom obnoviť zdravú črevnú mikrobiotu.
Diéta po liečbe Clostridium difficile
Po liečbe infekcie Clostridioides difficile je črevo často oslabené a črevná mikrobiota narušená, takže strava by mala byť ľahko stráviteľná, šetrná a podporná pre obnovu „dobrých“ baktérií.
Ľahká, nemastná strava – varené alebo dusené jedlá, žiadne vyprážané či ťažké jedlá.
Postupné zavádzanie vlákniny – začať s rozpustnou vlákninou (banán, ovsené vločky, mrkva, tekvica), nerozpustnú (celozrnné, surová zelenina) pridávať až neskôr.
Dostatok tekutín – voda, nesladený čaj, slabý vývar; vyhýbať sa sladeným a sýteným nápojom.
Menšie, častejšie porcie – nezaťažovať trávenie veľkými jedlami.
Podpora črevnej mikrobiota – dopnenie dobrých črevných baktérií v podobe probiotík, aby sa C. difficile nevrátila.
Prevencia Clostridium difficile:
- Racionálne používanie antibiotík: Užívanie antibiotík je potrebné vždy dobre zvážiť a užívať ich iba v nevyhnutných prípadoch.
- Hygiena: Dôsledné umývanie rúk najmä v zdravotníckych zariadeniach.
- Dezinfekcia: Používanie vhodných dezinfekčných prostriedkov na povrchy, ktoré môžu byť kontaminované.
- Podpora črevného mikrobiómu: Dôležitá je zdravá strava bohatá na vlákninu a užívanie probiotík, ktoré podporujú naše prospešné črevné baktérie.
Čím častejšie dostáva dieťa počas svojho vývoja (do 15 rokov) antibiotiká, tým vyššia je pravdepodobnosť vzniku zápalového ochorenia čriev, najmä Crohnovej choroby. Už po 7 antibiotikách je riziko 3-násobné.
Dôležitosť probiotík pri Clostridium difficile
Vedecké štúdie ukazujú, že riziko vzniku hnačky spojenej s Clostridium difficile sa zvyšuje s každým dňom, ktorý uplynie počas liečby antibiotikami bez užívania probiotík. Pretože antibiotiká sú dvojsečnou zbraňou: zatiaľ čo účinne ničia nežiaduce patogény, súčasne zabíjajú aj celý rad prospešných črevných baktérií. Tento narušený mikrobiálny ekosystém má vážne dôsledky nie len na trávenie a ale aj na celkový imunitný systém. Narušená črevná mikrobiota umožňuje rast a množenie patogénnych baktérií a ich toxínov.
Jednou z účinných stratégií, ako znížiť riziko infekcie Clostridium difficile je teda užívanie probiotík. Probiotiká obsahujú prospešné bakteriálne kmene, ktoré dokážu obnoviť rovnováhu črevného mikrobiómu a podporiť zdravé trávenie.
V rámci štúdie sa skúmal vplyv špeciálne vyvinutého viacdruhového probiotika na zloženie a frekvenciu stolice počas podávania antibiotík, najmä v priebehu chirurgických zákrokov a chemoterapie. Bakteriálne kmene obsiahnuté v probiotiku majú schopnosť vytláčať a aktívne ničiť patogénne baktérie, ktoré veľmi často spôsobujú hnačku, ako napríklad Clostridium difficile. Probiotiká nielenže znižujú pravdepodobnosť kolonizácie čreva patogénnymi baktériami, ale tiež zastavujú uvoľňovanie ich nebezpečných toxínov. Výsledky štúdie dokázali, že probiotiká môžu zastaviť uvoľňovanie toxínov Clostridium difficile už do 24 hodín od začiatku ich užívania.
Probiotiká k antibiotikám
Prevencia a liečba infekcie spôsobenej Clostridium difficile vyžaduje komplexný prístup. Clostridium difficile a rezistenica na antibiotiká je globálny problém. Riešenie si vyžaduje obmedzenie užívania antibiotík a vyššie hygienické štandardy. Užívanie probiotík počas liečby antibiotikami sa ukazuje ako účinná metóda na zníženie rizika vzniku infekcie Clostridium difficile. Udržiavanie rovnováhy črevného mikrobiómu je kľúčové nielen pre zdravé trávenie, ale aj pre prevenciu závažných infekcií, akou je Clostridium difficile.
Probiotické baktérie pozitívne pôsobia nielen priamo pri užívaní, ale dlhodobo prispievajú k rozvoju zdravej črevnej mikrobioty v priebehu niekoľkých týždňov. Špeciálne probiotiká obsahujúce laktobacily, bifidobaktérie a enterokoky, ktoré sú vhodné aj pre deti by sa mali užívať od prvého dňa antibiotickej liečby.